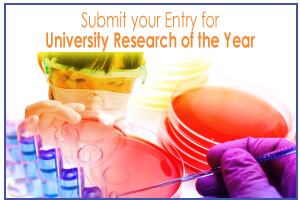

A new study that takes a ‘snapshot’ of the microbial make-up of Inuit guts could help nutrition researchers unravel how differences in traditional and modern diets have caused shifts in our microbome – and how these changes could be influencing health and disease risk.
Writing in mSphere, researchers from the University of Montreal in Canada reveal that stool samples taken from Inuit communities of the Canadian Arctic are indistinguishable from those of people living in the Canadian city of Montreal at the overall community level.
However, they said significant differences were found in the relative abundances of certain microbial taxa down to the subgenus level - indicating a similar kind of diet that is low in fibre, high in fat.
The finding is strange, because studies of the microbiome of other rural, indigenous, hunter-gatherer populations around the globe – particuarly in

Burkina Faso, Tanzania and Venezuela – have shown the opposite: There, people eat more vegetables and less meat, and the microbes in their gut are therefore more diverse.
“In contrast, the Inuit of the Canadian Arctic have been consuming a traditional diet low in carbohydrates and rich in animal fats and protein for thousands of years,” the research team wrote. “Like other native populations, the Inuit have a unique set of health risks, many of which could be modulated by the microbiome.”
Diet, the microbiome and health
Study leader Catherine Girard noted that there is strong evidence to suggest the human diet has a big influence on how our gut microbiome functions, and that the make-up of our gut bacteria consequently has a large impact on health and wellbeing.
"They're important to your health, they're unique to you, like a fingerprint, and the better we understand them, the more we'll all know about who we are,” said Girard.
The team noted it is unclear how the Inuit microbiome might contribute to different measures of health and risks of disease. For example, indigenous Arctic populations like the Alaskan Yup’ik Eskimo population have been found to have significantly lower risks of heart disease, while certain Inuit populations are said to be at a growing risk of obesity and type 2 diabetes.
“The Inuit harbor a diversity of gut microbes that is not strikingly different from that of their urbanised, Westernised counterparts,” said the team. “This may not reflect the ancestral Inuit microbiome: indeed, dietary transition and Westernisation, as well as the increasing prevalence of obesity, may have reduced diversity and changed the composition of the Inuit microbiome over time.”
NutraIngredients Awards 2017
University Research of the Year
Healthy foods, supplements, nutrients are built on sound research. Has your team been pushing the nutritional research envelope?
Study details
Girard and her colleagues compared the microbiome make-up of Inuit and Montreal populations using deep sequencing of the 16S rRNA gene in 19 Inuit and 26 Montreal-based stool samples.
While they found no ‘striking differences’ between the two seemingly very different populations in terms of their overall microbial community level, the team did note significant differences in levels of specific microbes.
For example, they found that Prevotella spp., which have been previously associated with high-fibre diets, were enriched in Montrealers and among the Inuit consuming a Western diet.
“The gut microbiomes of Inuit consuming a traditional diet also had significantly less genetic diversity within the Prevotella genus, suggesting that a low-fibre diet might not only select against Prevotella but also reduce its diversity,” said the authors.
“Other microbes, such as Akkermansia, were associated with geography as well as diet, suggesting limited dispersal to the Arctic,” they added.
“The Inuit diet provides an exception to the correlation between traditional diets and high microbial diversity, potentially due to their transitioning diet,” added the team – noting that knowledge of the Inuit microbiome could provide future insights on dietary intervention.
Source: mSphere
Published online, Open Access, doi: 10.1128/mSphere.00297-16
“Gut Microbiome of the Canadian Arctic Inuit”
Authors: Catherine Girard, Nicolas Tromas, Marc Amyot, B. Jesse Shapiro